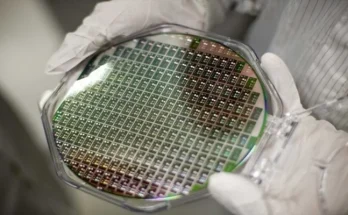

چیئرمین پاکستان ورچوئل ایسٹس ریگولیٹری اتھارٹی (پی یو اے آر اے) بلال بن ثاقب نے اعلان کیا ہےکہ پاکستان اپنی پہلی ’اسٹیبل کوائن‘ متعارف کرنے جا رہا ہے۔
پی یو اے آر اے ایک خود مختار وفاقی ادارہ ہے جسے متعدد اسٹیک ہولڈرز پر مشتمل بورڈ چلاتا ہے، جس میں گورنر اسٹیٹ بینک آف پاکستان، چیئرمین سکیورٹیز اینڈ ایکسچینج کمیشن آف پاکستان اور چیئرمین فیڈرل بورڈ آف ریونیو شامل ہیں۔
اس ادارے کا مقصد غیر قانونی مالیاتی سرگرمیوں کی روک تھام، صارفین کا تحفظ اور فِن ٹیک، ترسیلات، ٹوکنائزڈ اثاثوں اور شریعت سے مطابقت رکھنے والی جدت کے مواقع پیدا کرنا ہے جس کے لیے ریگولیٹری سینڈباکسز کا استعمال کیا جاتا ہے۔
بلومبرگ کے مطابق اسٹیبل کوائن ایک ایسا ڈیجیٹل ٹوکن ہوتا ہے جس کی قدر کسی حقیقی کرنسی، جیسے امریکی ڈالر کے ساتھ منسلک ہوتی ہے، جس کے باعث یہ بٹ کوائن جیسی کرپٹو کرنسیوں کے مقابلے میں زیادہ مستحکم ہوتا ہے۔
دبئی میں بنانس بلاک چین ویک سے خطاب کرتے ہوئے کرپٹو سربراہ نے کہا کہ پاکستان یقینا اسٹیبل کوائن لانچ کرے گا اور ملک اس کے ساتھ ساتھ سینٹرل بینک ڈیجیٹل کرنسی (سی بی ڈی سی) پر بھی کام کر رہا ہے۔
انہوں نے کہا کہ میرے خیال میں یہ حکومتی قرضے کو کولیٹرلائز کرنے کا بہترین طریقہ ہے، ہم اس مالیاتی ڈیجیٹل انویشن کے انتہائی اگلے محاذ پر رہنا چاہتے ہیں، جب ہمارے پاس صلاحیت بھی ہے اور عوامی اپنائیت بھی، تو ہم آخر میں کیوں رہیں؟
پاکستان کرپٹو کونسل (پی سی سی) کے مطابق بلال بن ثاقب نے ورچوئل اثاثوں کے مستقبل اور ابھرتی ہوئی مارکیٹوں میں ریگولیشن کے موضوع پر ایک پینل بحث میں بھی حصہ لیا۔
انہوں نے زور دیا کہ پاکستان جیسے ممالک کے لیے واضح اور جدت کو فروغ دینے والا کرپٹو ریگولیٹری فریم ورک معاشی ترقی کا بنیادی محرک ہے، پاکستان کے اسٹیبل کوائن، ڈیٹا فریم ورک اور بغیر بینک والے افراد کو باضابطہ نظام میں لانے کے اقدامات دنیا کے لیے مثالی کیس اسٹڈیز ثابت ہوسکتے ہیں۔
رواں برس کے اوائل میں بلال بن ثاقب نے ملک کا پہلا سرکاری سطح پر قائم کیا گیا اسٹریٹجک بٹ کوائن ریزرو بھی متعارف کرایا تھا۔
انہوں نے یہ اعلان لاس ویگاس میں ہونے والی ’بٹ کوائن ویگاس 2025‘ کانفرنس میں کیا، جہاں ان کے خطاب کے شرکا میں امریکی نائب صدر جے ڈی وینس، ایرک ٹرمپ اور ڈونلڈ ٹرمپ جونیئر بھی شامل تھے۔
مئی میں حکومت نے بٹ کوائن مائننگ اور مصنوعی ذہانت (اے آئی) کے ڈیٹا سینٹرز کے لیے پہلے مرحلے میں 2 ہزار میگاواٹ بجلی مختص کرنے کا اعلان کیا تھا۔